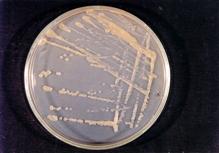

Bakteri nedir ?
Bakteriler, hücrelerinde hücre çekirdeği bulunmayan tek hücreli canlılardır. Yuvarlak, çubuk, virgül ve burgu şeklinde olurlar. Gözle görülmeyen bu canlıların bazı türleri bitkilerde, hayvanlarda veya insanlarda hastalık oluşturur.
Bitkilerde hastalık oluşturan bakterilere bitki patojeni bakteriler denir. Bitki patojeni bakteriler genelde çubuk şeklindedir, hareketlidir ve gelişmesi için uygun koşullar oluştuğunda çok hızlı çoğalırlar.
Bitki patojeni bakterileri yapay besi ortamında geliştirmek mümkündür.
Resim 33. Yapay besi ortamında geliştirilen bir bakterinin görünümü.
Bitki patojeni bakterilerin bitkilerde oluşturduğu belirti tipleri
Bugüne dek bilinen yaklaşık 1500 bakteri türünün 300 türü bitkilerde hastalık meydana getirir. Farklı bakteri türleri farklı bitki türlerini hastalandırır ve farklı belirtiler oluşturur. Bazı bakteri türleri çok sayıda bitki türünde hastalık oluştururken, bazıları tek bir konukçuya özelleşip sadece o bitki türünü hastalandırır. Bitkileri hastalandıran bakteriler bitkinin değişik organlarında hastalık belirtilerine neden olur. Bazı durumlarda bitkinin sadece bir organı etkilenirken bazen de pek çok organ birden zarar görür.
Bitki patojeni bakterilerin bitkilerde oluşturduğu belirti tiplerini gruplandırmak mümkündür. Bu belirti tipleri leke ve yanıklıklar, iletim demeti solgunlukları, geriye doğru ölüm ve kanserler, tümörler ve aşırı gelişmeler, yumuşak çürüklük ve uyuzlar ‘dır.
Leke ve yanıklıklara neden olan bakteriler bitkilerin yaprak, sap, gövde, çiçek ve meyvelerinde lekeler oluşturur. Lekeler önce suda haşlanmış görünümde olup daha sonra kahverengileşip kurur. Buğday, arpa, yulaf gibi tek çenekli bitkilerin yapraklarında oluşan lekeler çizgi veya şerit şeklindedir. Diğer bitkilerin yapraklarında oluşan lekeler bazen köşeli, bazen yuvarlak, bazı durumlarda ise açık sarı hale ile çevrilidir. Meyve lekeleri yuvarlak ya da biçimsiz olup bazı durumlarda çökük görünümlüdür. Leke yüzeylerinde nemli havalarda bakteriyel akıntı bulunur. Lekeler zamanla büyür ve birleşir. Böylece birleşen lekeler büyük alanların kurumasına ve bitki yüzeyini yaygın olarak tahrip ederek yanıklıkların oluşmasına neden olur. Domates bakteriyel benek hastalığı bu grubun önemli temsilcilerindendir. Hastalık ülkemizde hem örtü altında hem de tarlada görülür. Hastalık belirtileri fidelerde ve daha sonra bitkinin tüm toprak üstü kısımlarında oluşur. Yapraklarda oluşan lekeler hale ile çevrilidir. Meyvede toplu iğne başını andıran lekeler birleşince meyvenin şeklini bozar.
Domates bakteriyel benek hastalığının belirtileri

Resim 34. Fidedeki belirti.

Resim 35. Yapraktaki belirti.

Resim 36. Meyvedeki belirti.
Bu grupta yer alan diğer bir hastalık Domates ve biberde bakteriyel leke hastalığıdır. Bu hastalığın oluşturduğu lekeler Domates bakteriyel benek hastalığının belirtilerine benzer. Ancak oluşan lekeler daha büyük ve daha düzensiz, meyvelerde oluşan lekeler ise üstten bakılınca çukur görünüşe sahiptir. Hastalık domatesin dışında biberde de çok yıkıcı olabilir.

Resim 37. Bakteriyel leke hastalığının yaprak ve meyvede oluşturduğu belirtiler.
Hıyar köşeli yaprak lekesi hastalığı yapraklarda damarlar arasında köşeli, meyvelerde ise yuvarlak hafifçe çökük lekelerin oluşumuna neden olur.

Resim 38. Hıyar köşeli yaprak leke hastalığının belirtileri.

Resim 39. Fasulye hale yanıklığı hastalığı.
Fasulyede görülen Hale yanıklığı ve Adi yaprak yanıklığı hastalıklarında yapraklarda önce lekeler oluşur, daha sonra lekeler birleşerek geniş alanları kapsayan yanıklık meydana getirir. Fasulye hale yanıklığı hastalığında lekenin çevresinde açık sarı renkte büyük hale oluşur Adi Yaprak yanıklığı hastalığında ise oluşan lekeler daha büyük etrafında oluşan hale ise dar ve sınırlıdır. Bu hastalıklarda kapsüller de etkilenir ve üzerinde lekeler görülür.

a-yaprak belirtileri; b-kapsül belirtileri
Resim 40. Fasulye adi yaprak yanıklılığının belirtileri.
İletim demeti solgunluklarına neden olan bakteriler bitkinin iletim demetlerinin tıkanmasına yol açar. İletim demetleri bitkide su ve besin iletimini sağlar. İletim demetlerinin tıkanması su ve besin iletiminin engellenmesi anlamına gelir. Bunun sonucunda bitkilerde bodurlaşma, solgunluk ve kuruma meydana gelir. İletim demeti solgunluğuna neden olan bakteriler genelde sebze, süs, tarla ve tropik bitkilerini etkiler.
Domates bakteriyel kanser ve solgunluk hastalığı çok tipik bir iletim demeti hastalığıdır. Ülkemizde örtü altı ve tarla yetiştiriciliğinde görülen hastalık alt yapraklardan başlayarak bitkilerin solmasına ve daha sonra kurumasına neden olur.

a-bitkideki belirtileri. b- meyvedeki belirtileri.
Resim 41. Domates bakteriyel kanser ve solgunluk hastalığının belirtileri.
Domates öz (gövde) nekrozu hastalığı kahverengi-siyah gövde lekelerin oluşumuna ve öz dokusunun parçalanma, siyahlaşma ve boşalmasına neden olur. Hastalığı meydana getiren bakteriler bitkinin iletim demetini etkilediğinden solgunluk meydana gelir.

Resim 42. Nekrozun öz dokuda belirtisi.

Resim 43. Hastalığın gövdede lekeleri ve solgunluk.
Geriye doğru ölüm ve kanserlere neden olan bakteriler genelde meyve ağaçlarında belirti oluşumuna yol açar. Bu belirtiler tomurcuk yanıklığı, çiçek yanıklığı, sürgün yanıklığı, geriye doğru ölüm şeklinde görülen dal yanıklığı, dal ve gövde üzerinde kahverengi çökük alanların oluşumu ve dal ve gövdelerde derin çatlaklar şeklinde seyreden kanser belirtileridir. Kanserler dalı sardığında dal kurur. Bazı durumda bu belirtiler fungal etmenlerin meydana getirdiği belirtilere benzer. Ülkemizde bu grubun en önemli temsilcileri Yumuşak çekirdekli meyve ağaçlarında ateş yanıklığı ve Sert çekirdekli meyve ağaçlarında bakteriyel kanser ve zamklanma hastalıklarıdır.
Yumuşak çekirdekli meyve ağaçlarında Ateş yanıklığı hastalığının en tipik belirtisi hasta kısımların ateşten yanmış bir görünüm almasıdır. Hastalık çiçek yanıklığı, sürgün yanıklığı, yaprak yanıklığı, meyve yanıklığı, ana dal ve gövde yanıklığı, kök boğazı, kök ve anaç yanıklığı şeklinde görülebilir. H

Resim 44. Çiçek yanıklığı.

Resim 45. Dal yanıklığı.

Resim 46. Gövdede oluşan kanser.
Sert çekirdekli meyve ağaçlarında bakteriyel kanser ve zamklanma hastalığında genç sürgün, dal ve gövde üzerinde kanserler oluşur. Kanser yüzeyleri yumuşak, ıslak, ve güneş yanığı görünümde olup ekşi bir kokuya sahiptir. Kanser yüzeyinde zamk çıkışı gözlenir. Kanserler genellikle dalların budanan kısımlarında veya yara yerlerinde gelişir. Kabuğun hasta kısmı yumuşar ve sonra hafifçe çöker. Hasta kabuk dalı çepeçevre sararsa dal veya gövde tamamen ölebilir. •Genç
Tümörler ve aşırı gelişmelere neden olan bakteriler bitkinin farklı organlarında, özellikle kök, kök boğazı ve gövdede gal veya urlar oluştururlar. Oluşan gal veya urlar önceleri açık krem renginde ve yumuşaktır. Daha sonra yaşlandıkça kahverengileşir ve sertleşirler. Bu grupta yer alan en önemli bakteriyel hastalıklar yumuşak ve sert çekirdekli meyve ağaçlarında görülen Kök kanseri, Asma kök uru, Zeytin dal kanseri ve Badem dal kanseri hastalığıdır.

Resim 47. Kök kanseri hastalığının belirtileri.

Resim 48. Asma kök uru hastalığı.
Kök kanseri hastalığı pek çok meyve ve bazı orman ağaçlarının kök ve kök boğazında görülür. Bu bitkilerin dışında pamuk, domates, krizantem, gül, tütün v.s. gibi bitkilerde de gözlenebilir. Kök boğazında veya köklerde değişik büyüklükte urlar oluşur Asma kök uru hastalığında da kök boğazı, kök, gövde veya sürgünlerde urlar oluşur.
Zeytin dal kanseri hastalığında gövde, dal ve sürgünlerde değişik büyüklükte ur ve siğiller oluşur
Badem dal kanseri hastalığında sürgün, dal ve gövdede kahverengi kanser yaraları meydana gelir. Kış sonlarında daha ağaçlar uyku devresinde iken yaprak döküm yerlerinde kabuk kısmında zamanla uzunlamasına bir çatlaktan odun dokusuna yayılan şişkinlikler oluşur.

Resim 49. Zeytin dal kanseri hastalığı urları.
Yumuşak çürüklüğüne neden olan bakteriler genellikle sebze ve süs bitkilerini etkiler. Belirti yumruda, yapraklarda, gövde ve sürgünlerde görülebilir. Sulu ve körpe dokulara sahip olan sebzeler daha çok etkilenir. Bu belirti tipi en çok sulu depo organlarına sahip patates, havuç, turp, soğan, meyvesi körpe olan hıyar, kabak, patlıcan, domates, yaprakları sulu lahana, marul, kereviz, ıspanak gibi bitkilerde görülür. Belirtiler tarlada veya depoda ortaya çıkabilir ve çok ciddi kayıplar meydana gelebilir. Belirtiler tüm konukçularda benzer şekilde ortaya çıkar. öncelikle doku üzerinde küçük suda haşlanmış görünümlü leke oluşur. Bu leke hızla büyür ve kısa sürede tüm alanı kapsayabilir. Etkilenen alanda dokularda yumuşama, sulanma ve çürüme görülür.
Patates bakteriyel yumuşak çürüklüğü hastalığı önce tarlada kendini belli eder. Bitkilerin gelişmesinde durgunluk, çalılaşma ve bodurlaşma gözlenir. Gövdede en sık görülen belirti karabacak veya dip yanıklığı adı verilen bitki gövdesinin hemen toprak üstündeki kısmında siyahlaşma ve yumuşama şeklinde gözlenen belirtidir. Hastalığın ikinci kademesi yumrularda görülür. Hasta yumrularda önce krem-beyaz ve sulu bir çürüme gözlenir. Bu çürüme daha sonra yumrunun tamamını kapsar ve pis bir koku yayılır

Resim 50. Patates bakteriyel yumuşak çürüklüğü hastalığının belirtileri.
Yumuşak çürüklüğüne neden olan bazı bakteriler domates gövde çürüklüğü belirtisini meydana getirirler. Bu durumda gövdelerde sulu bir çürüme ve gövde boşalması görülür.

Resim 51. Domateste gövde çürüklüğü belirtisi.
Enginar yaş çürüklüğü hastalığında enginar çiçek goncasındaki yaprak kısmında siyahlaşma ve çürüme meydana gelir.

Resim 52. Enginar yaş çürüklüğü hastalığının belirtileri.
Uyuza neden olan bakteriler patates, lahana, hayvan pancarı, havuç, turp, köpek üzümü ve patlıcan gibi bitkilerin toprakaltı organlarında belirti oluşturur. Bu bitkilerin arasında en fazla etkilenen bitki patatestir. Patates yumrularında kabukta değişik biçim ve derinlikte lekeler oluşur. Yüzeysel, derin ve kabarık uyuz olarak bilinen üç tip uyuz vardır. Yüzeysel uyuzda lekeler kabuğun yüzeyinde kalır derine inmezler. Derin uyuzda lekeler yumru yüzeyinden derine iner. Kabarık uyuzda ise yumruda kabuk yüzeyinde siğilimsi çıkıntılar ya da kabarıklıklar dikkat çeker. Patates uyuzu verim kaybından çok pazar değerinin kaybına yol açar.

Resim 53. Yüzeysel uyuz.

Resim 54. Kabarık uyuz.

Resim 55. Derin uyuz.
Bitki patojeni bakterilerin bitkiye giriş yolları
Bitki patojeni bakteriler yaralardan veya bitki yüzeyinde bulunan doğal açıklardan bitki dokusuna giriş yaparlar. Yaralar mekanik yolla insanlar veya hayvanlar tarafından açılabilir veya dolu, rüzgar veya don sonrası oluşabilirler. Bakteriler bol sulu, kolay yaralanabilen genç dokulara daha kolay giriş yaparlar. Bu nedenle bu tip dokular bakteriyel hastalıklara daha elverişlidir.
Bitki patojeni bakterilerin yayılma yolları
Bitki patojeni bakteriler bitki içinde bir organdan diğerine sıçrayabilirler, örneğin yapraktan meyveye geçebilirler. Bu durumda bitkinin tümünün hastalanması söz konusu olabilir. Bakteriler bitkiden bitkiye de yayılabilir. Bir bitkiden diğerine geçerek tüm tarla veya bahçedeki bitkilerin hastalanmasına daha sonra ise hastalığın tarladan tarlaya ve böylece tüm bölgeye veya ülkeye yayılmasına yol açabilirler. Bakteriler ülke sınırı içersinde kalmayıp ülkeler arası hatta kıtalar arası yayılabilirler.
Bitki patojeni bakterilerin farklı yayılma yolları vardır. Bu yollar üretim materyali, toprak, su, rüzgar, böcekler, diğer hayvanlar veya insanlardır. Bitkiden bitkiye veya yakın tarlalar arası yayılma olarak tarif edilebilen kısa mesafeli yayılmada tüm sayılan yollar önemli iken ülkeler veya kıtalar arası uzun mesafeli yayılmada üretim materyali ve insanlar yoluyla yayılma ön plana çıkar.
Üretim materyali (tohum, fide, fidan) bakterilerin kısa mesafeli de olduğu gibi uzak mesafeli yayılmasında da çok önemlidir. Bulaşık tohum, fide veya fidan ticareti bakterinin bölgeler arası, ülkeler arası veya kıtalar arası yayılmasını sağlar. Bulaşık tohum veya fidanlar bakterilerin yıldan yıla geçişinde de önem taşır. Bulaşık üretim materyali ile üretime başlanması bir sonraki yıl hastalığın görülmesi anlamına gelir.
Toprak, toprak kaynaklı bakterileri veya hastalıklı bitki artışlarını barındırır. Toprak işleme veya sulama ile toprak kaynaklı bakteriler tarlalar arası geçiş yapabilirler. Bulaşık toprak bakterilerin yıldan yıla geçişini sağlar.
Su yağmur veya sulama suyu şeklinde bakterilerin yayılmasında etkili olur. özellikle rüzgarlı yağmurlar bakterilerin yayılmasında çok önemlidir. Sulama şekli ayrı bir önem taşır. Yağmurlama sulama bitkinin yeşil aksamında hastalık oluşturan bakterilerin yayılmasında son derece önemlidir. Toprakta yaşayan bakterilerin yayılmasında ise salma sulama etkili olur.
Rüzgar bitkilerde yaralar açarak ve bakterileri sürükleyerek yeni bulaşmalara yol açar. Bu anlamda özellikle yağmurlu rüzgarlar çok önemlidir.
Böcekler bazı bakterilerin yayılmasında önemli rol oynarlar. Böcekler bakterilerin bitkiden bitkiye ulaşmasını sağladıkları gibi beslenmeleri sırasında açtıkları yaralarla ya da bakteriyi doku içine sokarak bakteriyi bitkiye kolayca bulaştırabilirler. Bazı durumlarda böcekler bakteriyi bünyelerinde barındırabilir ve bakterinin yaşamını sürdürmesinde ve yıldan yıla geçişinde de etkili olurlar. Böcekler bazı bakterilerin yaşamını sürdürebilmesi için zorunludur, bazıları için ise zorunlu değildir.
Hayvanlar (kuşlar, tavşanlar, nematodlar v.s.) bakterilerin yayılmasında etkili olurlar. Bunlar bitkileri ziyaret ederek veya bitkilerin arasında dolaşarak bakterilerin bitkiden bitkiye geçişini sağlayabilirler.
İnsanlar bitkiler arasında dolaşarak bakım işlemleri sırasında bakterileri yayabilirler. Ayrıca tarım makinalarını kullanarak açtıkları mekanik yaralarla bulaşmayı teşvik ettikleri gibi bulaşık bitki materyalini uzaklara taşıyarak uzun mesafeli yayılmayı kolaylaştırırlar.
Facebook'ta Yayınla>